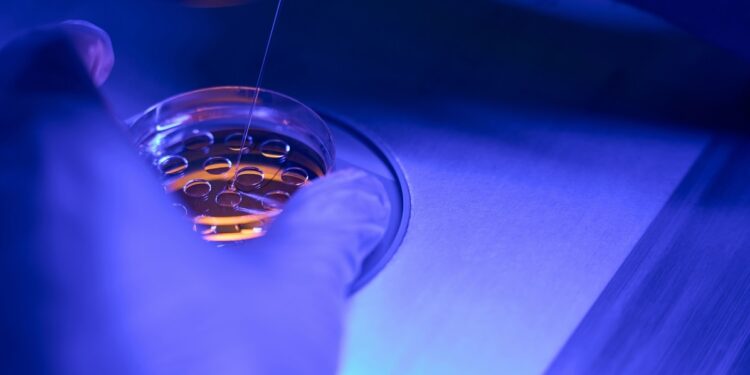
Moderne genomale analyse in de klinische praktijk: CMA en NGS

De Associatie van medische genetici van Griekenland (Sige), in samenwerking met het Laboratorium voor medische biologie en genetica van het Department of Medicine Auth, organiseert een workshop met als thema ‘Genomale analyse in de klinische praktijk: het gebruik van moleculair karyotype (CMA) en volgende-generatie-sequentie (NGS)’. Deze workshop zal plaatsvinden op 13-14 juni 2025, in het Centrum voor de verspreiding van onderzoeksresultaten (Kedea) van de Aristoteles University of Thessaloniki.
De workshop is gericht op artsen en professionals in de gezondheidszorg die geïnteresseerd zijn in genetica en beoogt voorbeelden te presenteren van genetische incidenten met het gebruik van de belangrijkste technieken van genetische/genomische analyse (NGS & CMA) die momenteel worden gebruikt bij genetische diagnose. Tijdens de workshop zullen de methodologie, de informatie in een genetisch controleverslag en de mogelijke moeilijkheden die zich voordoen bij het interpreteren van resultaten worden uitgelegd.
De CMA-techniek, ofwel moleculair karyotype, is een geavanceerde methode voor genetische analyse die het mogelijk maakt om chromosomale afwijkingen op te sporen. Door het analyseren van het hele genoom op microscopisch niveau kunnen afwijkingen zoals duplicaties, deleties en andere structurele veranderingen worden gedetecteerd. Deze techniek is vooral nuttig bij het diagnosticeren van aangeboren afwijkingen en genetische aandoeningen.
Daarnaast zal tijdens de workshop ook de NGS-techniek worden besproken. NGS, of volgende-generatie-sequentie, is een geavanceerde methode voor het sequencen van het volledige genoom van een individu. Deze techniek maakt het mogelijk om mutaties in specifieke genen op te sporen en kan worden toegepast bij het diagnosticeren van erfelijke ziekten, het voorspellen van risico’s voor bepaalde aandoeningen en het personaliseren van behandelingen.
Het begrijpen en toepassen van deze geavanceerde genetische technieken is essentieel voor het verbeteren van de klinische praktijk en het bieden van gepersonaliseerde zorg aan patiënten. Door middel van genoomanalyse kunnen artsen en genetici beter begrijpen welke genetische factoren ten grondslag liggen aan bepaalde aandoeningen en kunnen zij gerichtere behandelingen voorschrijven.
Al met al belooft de workshop ‘Genomale analyse in de klinische praktijk’ een waardevolle gelegenheid te zijn voor professionals in de gezondheidszorg om hun kennis en vaardigheden op het gebied van genetica en genomica te vergroten en zo de zorg voor patiënten te verbeteren. Meedoen aan deze workshop kan bijdragen aan een beter begrip van genetische aandoeningen en het ontwikkelen van effectievere behandelingsstrategieën.